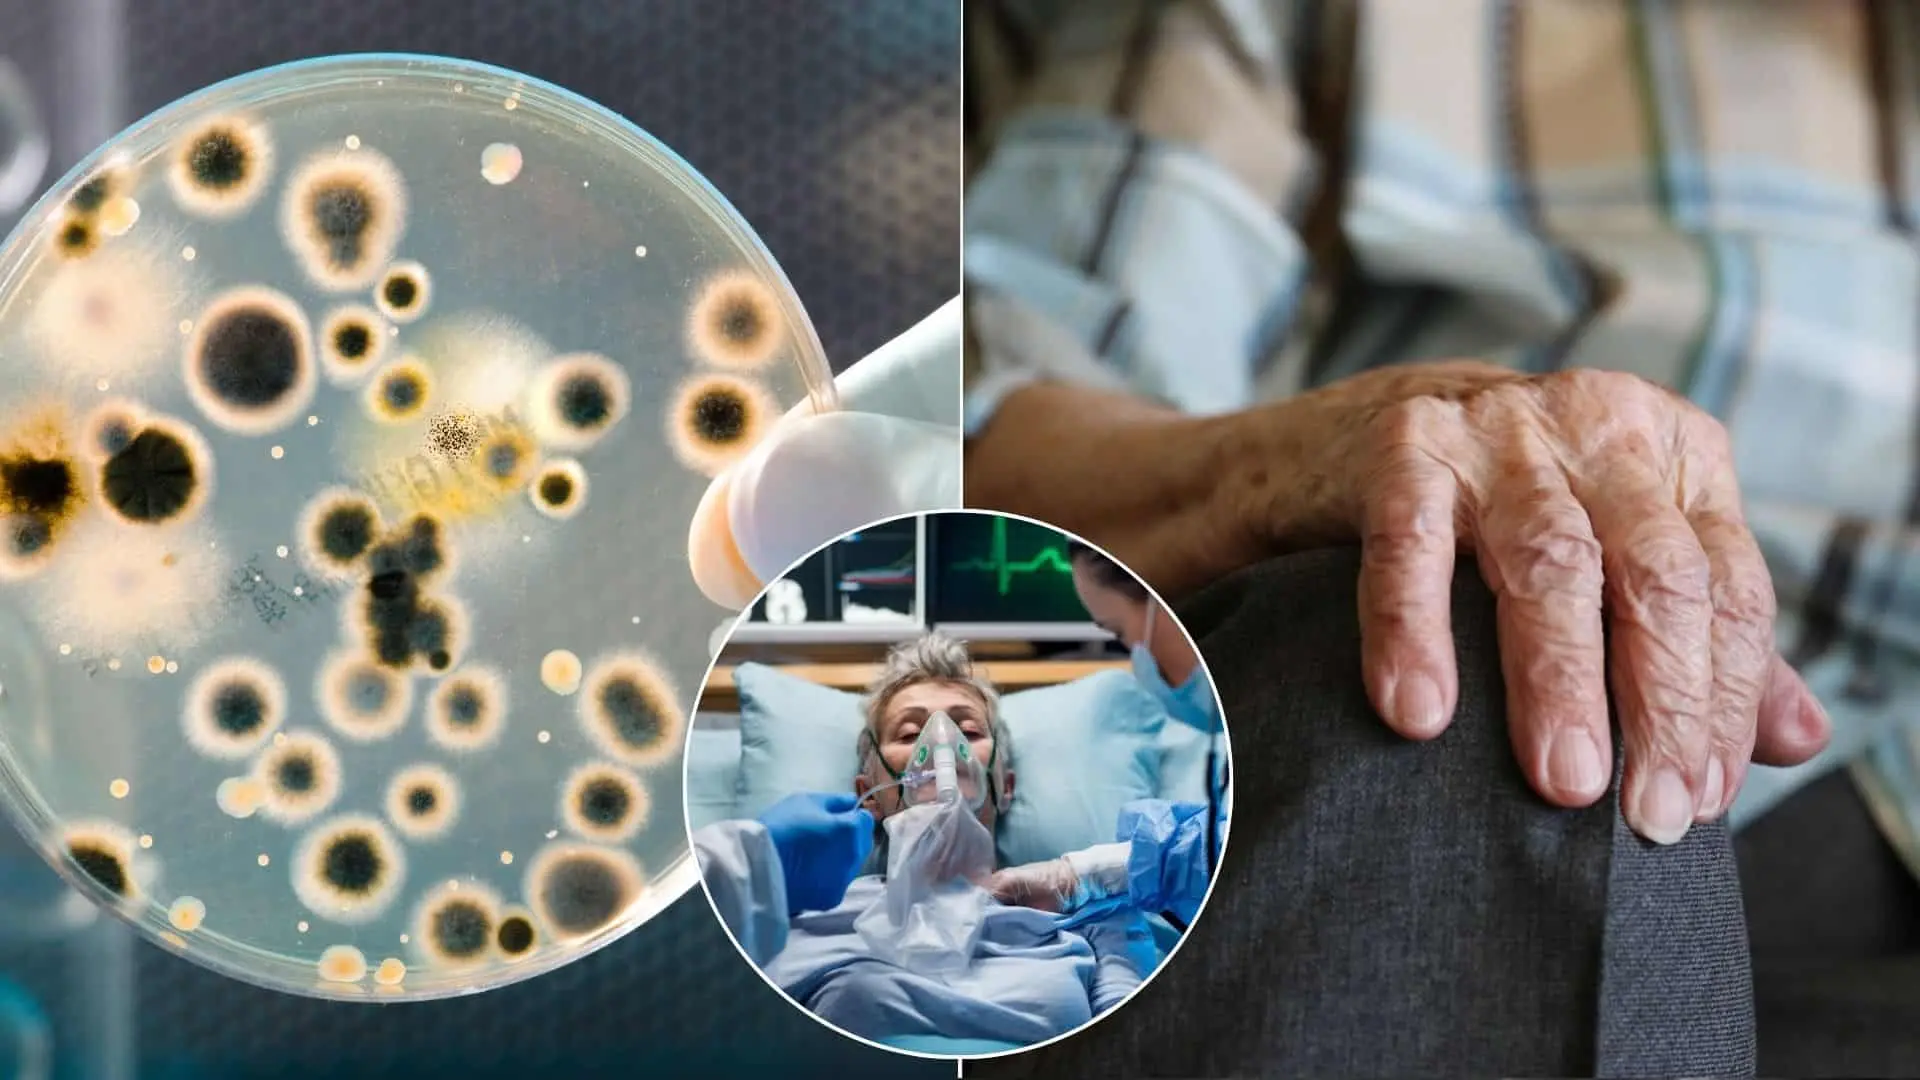

Relax vo vírivke sa pre skupinu seniorov zmenil na tragédiu. Po pobyte v hoteli v Demänovskej doline sa viacerí účastníci výletu nakazili nebezpečnou baktériou legionelou. Jedna žena zomrela, ďalší skončili v nemocnici. Hygienici medzičasom odhalili alarmujúce zistenia vo vode wellness zariadenia.
Pobyt, ktorý mal seniorom priniesť oddych a nové sily, sa premenil na katastrofu. Skupina z Pezinka si začiatkom júna naplánovala relaxačný výlet do Nízkych Tatier. Lenže krátko po návrate viacerí účastníci ochoreli – niektorých museli hospitalizovať a 65-ročná Mária napokon zomrela. Príčinou bola legionela – baktéria, ktorá sa šíri cez kontaminovanú vodu, informuje denník Nový čas.
Podľa Regionálneho úradu verejného zdravotníctva (RÚVZ) v Bratislave sa z 45 účastníkov výletu nakazilo šesť ľudí, z toho štyria mali infekciu laboratórne potvrdenú. „V uvedenej súvislosti bolo zaznamenané aj 1 úmrtie,“ potvrdila hovorkyňa RÚVZ Katarína Nosálová. Baktéria Legionella pneumophila sa najčastejšie vyskytuje v teplej vode a vírivkách – a práve wellness zariadenie v jednom z hotelov v Demänovskej doline sa stalo hlavným podozrivým.
Horúčky, hospitalizácie a dramatický vývoj
Jednou z pacientiek bola aj Magda, ktorá opísala rýchly priebeh ochorenia jej mamy: „Moja mamina mala vysoké horúčky. V sobotu bola na pohotovosti. Predpísali jej antibiotiká. V pondelok bola u svojho obvodného lekára. V utorok ráno mala výsledky z röntgenu, bol urobený odber krvi, v ten istý deň – večer bola hospitalizovaná.“ Vďaka včasnej liečbe sa jej stav stabilizoval a po niekoľkých dňoch mohla odísť domov.

Máriu však infekcia skolila – ochorenie na legionelózu prebieha rýchlo a môže byť smrteľné, najmä u starších ľudí alebo osôb s oslabenou imunitou. V súčasnosti je na jednotke intenzívnej starostlivosti hospitalizovaný ešte jeden ďalší účastník zájazdu.
Vyšetrovanie odhalilo viac než len legionelu
Prípad si okamžite prevzali hygienici z Liptovského Mikuláša, ktorí začali s kontrolami priamo v hoteli. Z viacerých častí objektu, vrátane wellness centra, odobrali vzorky vody. Výsledky laboratórnych testov boli alarmujúce – vo vírivke našli nielen legionelu, ale aj zvýšené množstvo kultivovateľných mikroorganizmov a nebezpečnú baktériu Pseudomonas aeruginosa. Tá môže spôsobiť vážne infekcie, ako je zápal močových ciest, zápal stredného ucha či komplikácie po popáleninách, a je odolná voči mnohým antibiotikám.
Regionálna hygienička Iveta Triznová potvrdila, že wellness zóna bola po zistení okamžite uzavretá a hotel musel prijať viaceré opatrenia. Ďalšie testy vody – vrátane tej z kuchyne a bazéna – v minulosti prítomnosť legionely nepreukázali. Koncom júna však odobrali nové vzorky z izieb a ich analýza stále prebieha. „Ďalšie kroky závisia od výsledkov aktuálnych vyšetrení,“ uviedla Triznová.
Tragédia z Demänovskej doliny tak opäť upozorňuje na potrebu prísnej kontroly hygieny v rekreačných zariadeniach, najmä tých, ktoré ponúkajú wellness služby. Aj zdanlivo neškodný relax vo vírivke môže mať fatálne následky.
Čo je legionárska choroba?
Legionárska choroba je podľa portálu Legionella závažná forma zápalu pľúc, ktorú spôsobuje baktéria Legionella pneumophila. Infekcia najčastejšie vzniká vdýchnutím aerosólu obsahujúceho legionelly – napríklad z víriviek, klimatizácií, sprchovacích hlavíc alebo iných vodných systémov, kde sa voda zahrieva a cirkuluje.
Choroba sa obvykle prejaví 2 až 10 dní po vystavení baktériám a medzi hlavné príznaky patrí
- vysoká horúčka,
- zimnica,
- slabosť,
- bolesť hlavy, svalov
- a suchý kašeľ.
V niektorých prípadoch môže dôjsť aj k vykašliavaniu hlienov či krvi, bolestiam na hrudi, dýchavičnosti, hnačke a zmätenosti. Najviac ohrození sú ľudia s oslabenou imunitou, starší pacienti a fajčiari. Bez včasnej liečby môže byť priebeh ochorenia vážny, dokonca aj smrteľný. Diagnostika si vyžaduje špecifické testy, pretože príznaky môžu pripomínať bežnú chrípku alebo inú formu zápalu pľúc. Liečba spočíva v podávaní antibiotík a podporných terapiách zameraných na zvládnutie príznakov a ochranu orgánových funkcií.